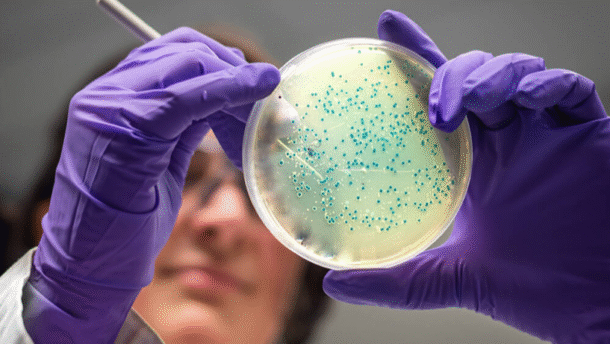

Вагінальна трихомонада (Trichomonas vaginalis) – паразитарний збудник урогенітальної інфекції: діагностика, лікування та профілактика
У медичному центрі «Альтернатива» застосовується комплексний підхід до діагностики, терапії та профілактики трихомоніазу, що включає сучасні протипротозойні препарати, озонотерапію, відновлення мікрофлори та детоксикацію організму. Методи озонотерапії: внутрішньовенне введення озонованого фізіологічного розчину, проведення великої аутогемоозонотерапії, вагінальні інсуфляції озоно-кисневою сумішшю